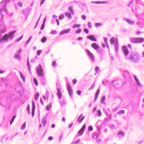
MENDEL MASTERY SERIES™: BONE TUMORS

Advanced Pathology Prep.
Mendel Mastery Series.
- Ideal for MD, DNB, NEET-SS (India), ABPath (USA), and FRCPath (UK) aspirants
- Trusted by Doctors & Alumni in India, SEA, UAE, USA, Caribbean, & Canada
- For Pathology Residents, Fellows, and Consultants
Pathology Mastery Series Challenge
Can you diagnose these?

Schistosomiasis

Multiple Myeloma

FISH: Liposarcoma

Colon cancer

Pleomorphic liposarcoma

Colorectal cancer

Polyp with cancer

Chondrosarcoma

Abnormal mitosis

Chondrosarcoma - gross

IHC: In germinal center

Kidney FSGS

Perineural tumor invasion

Donut granuloma, Q fever
Master pattern recognition with Mendel Academy’s case based mentoring.
Advanced Endometrial Pathology Program
Comprehensive training program designed to enhance your diagnostic confidence in complex endometrial pathology cases

Interpretation of Endometrial Biopsies
Master the complexities of endometrial pathology with confidence

Dr. Nandkishore Managoli
MD, Senior Surgical & Digital Pathologist
“Focused on advancing diagnostic accuracy through systematic evaluation approaches and evidence-based practice.”
What You'll Master:
Course Includes:
Small cohort sizes ensure personalized attention • Expert-led instruction
Pathology Mendel Mastery Series™! Watch & Learn Anytime
Your all-in-one, deep-dive into each pathology subject—covering everything you need to master topics like Lymphomas, case by case.
MENDEL MASTERY SERIES™: LYMPHOMAS

Curriculum aligned with WHO 5th Ed. Blue Book
6 months access
$59.99
E-certificate included | CV + CME friendly | One-Time payment
MENDEL MASTERY SERIES™: BONE TUMORS

65+ cases of Bone Tumors: WHO blue book, 5th Ed.
6 months access
$49.99
E-certificate included | CV + CME friendly | One-Time payment
MENDEL MASTERY SERIES™: BONE & SOFT-TISSUE TUMORS

300+ cases of Bone & Soft tissue Tumors: WHO 5th Ed.
6 months access
$59.99
E-certificate included | CV + CME friendly | One-Time payment
MENDEL MASTERY SERIES™: ENDOSCOPIC GI BIOPSIES

🏆 Our Most Popular Course - 100+ enrolled
6 months access
$59.99
E-certificate included | CV + CME friendly | One-Time payment
Pre-recorded HD video lectures | 23+ hours of expert-led content | 1000+ annotated gross & micro images | High-yield, case-based learning | e-Certificate + CME credits after test
BUNDLE MORE. SAVE MORE.
Add another Mendel Mastery course & get 10% OFF. Stack it up & get up to 20% OFF when you bundle all 3!
- 1 course = regular price
- 2 courses = 10% off total
- 3 courses = 20% off total
Upcoming Courses
Expand your expertise with additional subspecialty training courses launching throughout 2025. Join the waitlist to get early access and exclusive updates.

Interpretation of Bone Marrow Biopsies
Advanced training in bone marrow biopsy interpretation for hematopathology specialists.

Interpretation of Renal Biopsies
Comprehensive training in renal pathology with focus on glomerular and tubulointerstitial diseases.

Interpretation of Liver Biopsies
Modern approach to liver pathology including fatty liver disease, hepatitis, and cirrhosis.
Never Miss a Course Launch
Get the latest updates on our upcoming courses, early bird pricing, and exclusive content from our expert instructors.
Join 10,000+ medical professionals • Unsubscribe anytime
What Mendel Students Have To Say About Us
Meet Your Mentor

Dr. Kishor Managoli, MD
Senior Surgical & Digital Pathologist
Founder & Chief Educator, Mendel Academy
Dr. Managoli is popular for providing his students a transformational experience. His mentorship is deeply interactive and case-based, designed to help you think critically, diagnose confidently, and connect pathology to real clinical decisions. Every session challenges you to engage, question, and evolve, not just as a learner, but as a future leader in diagnostics. Under his mentorship, you will build a strong foundation in surgical pathology, master digital techniques, and develop critical thinking skills essential for diagnostic excellence.
 30+ years of Surgical & Pathology experience
30+ years of Surgical & Pathology experience Actively involved in stem cell research
Actively involved in stem cell research 15 years of clinical research in the U.S.
15 years of clinical research in the U.S. 8 U.S. patents
8 U.S. patents